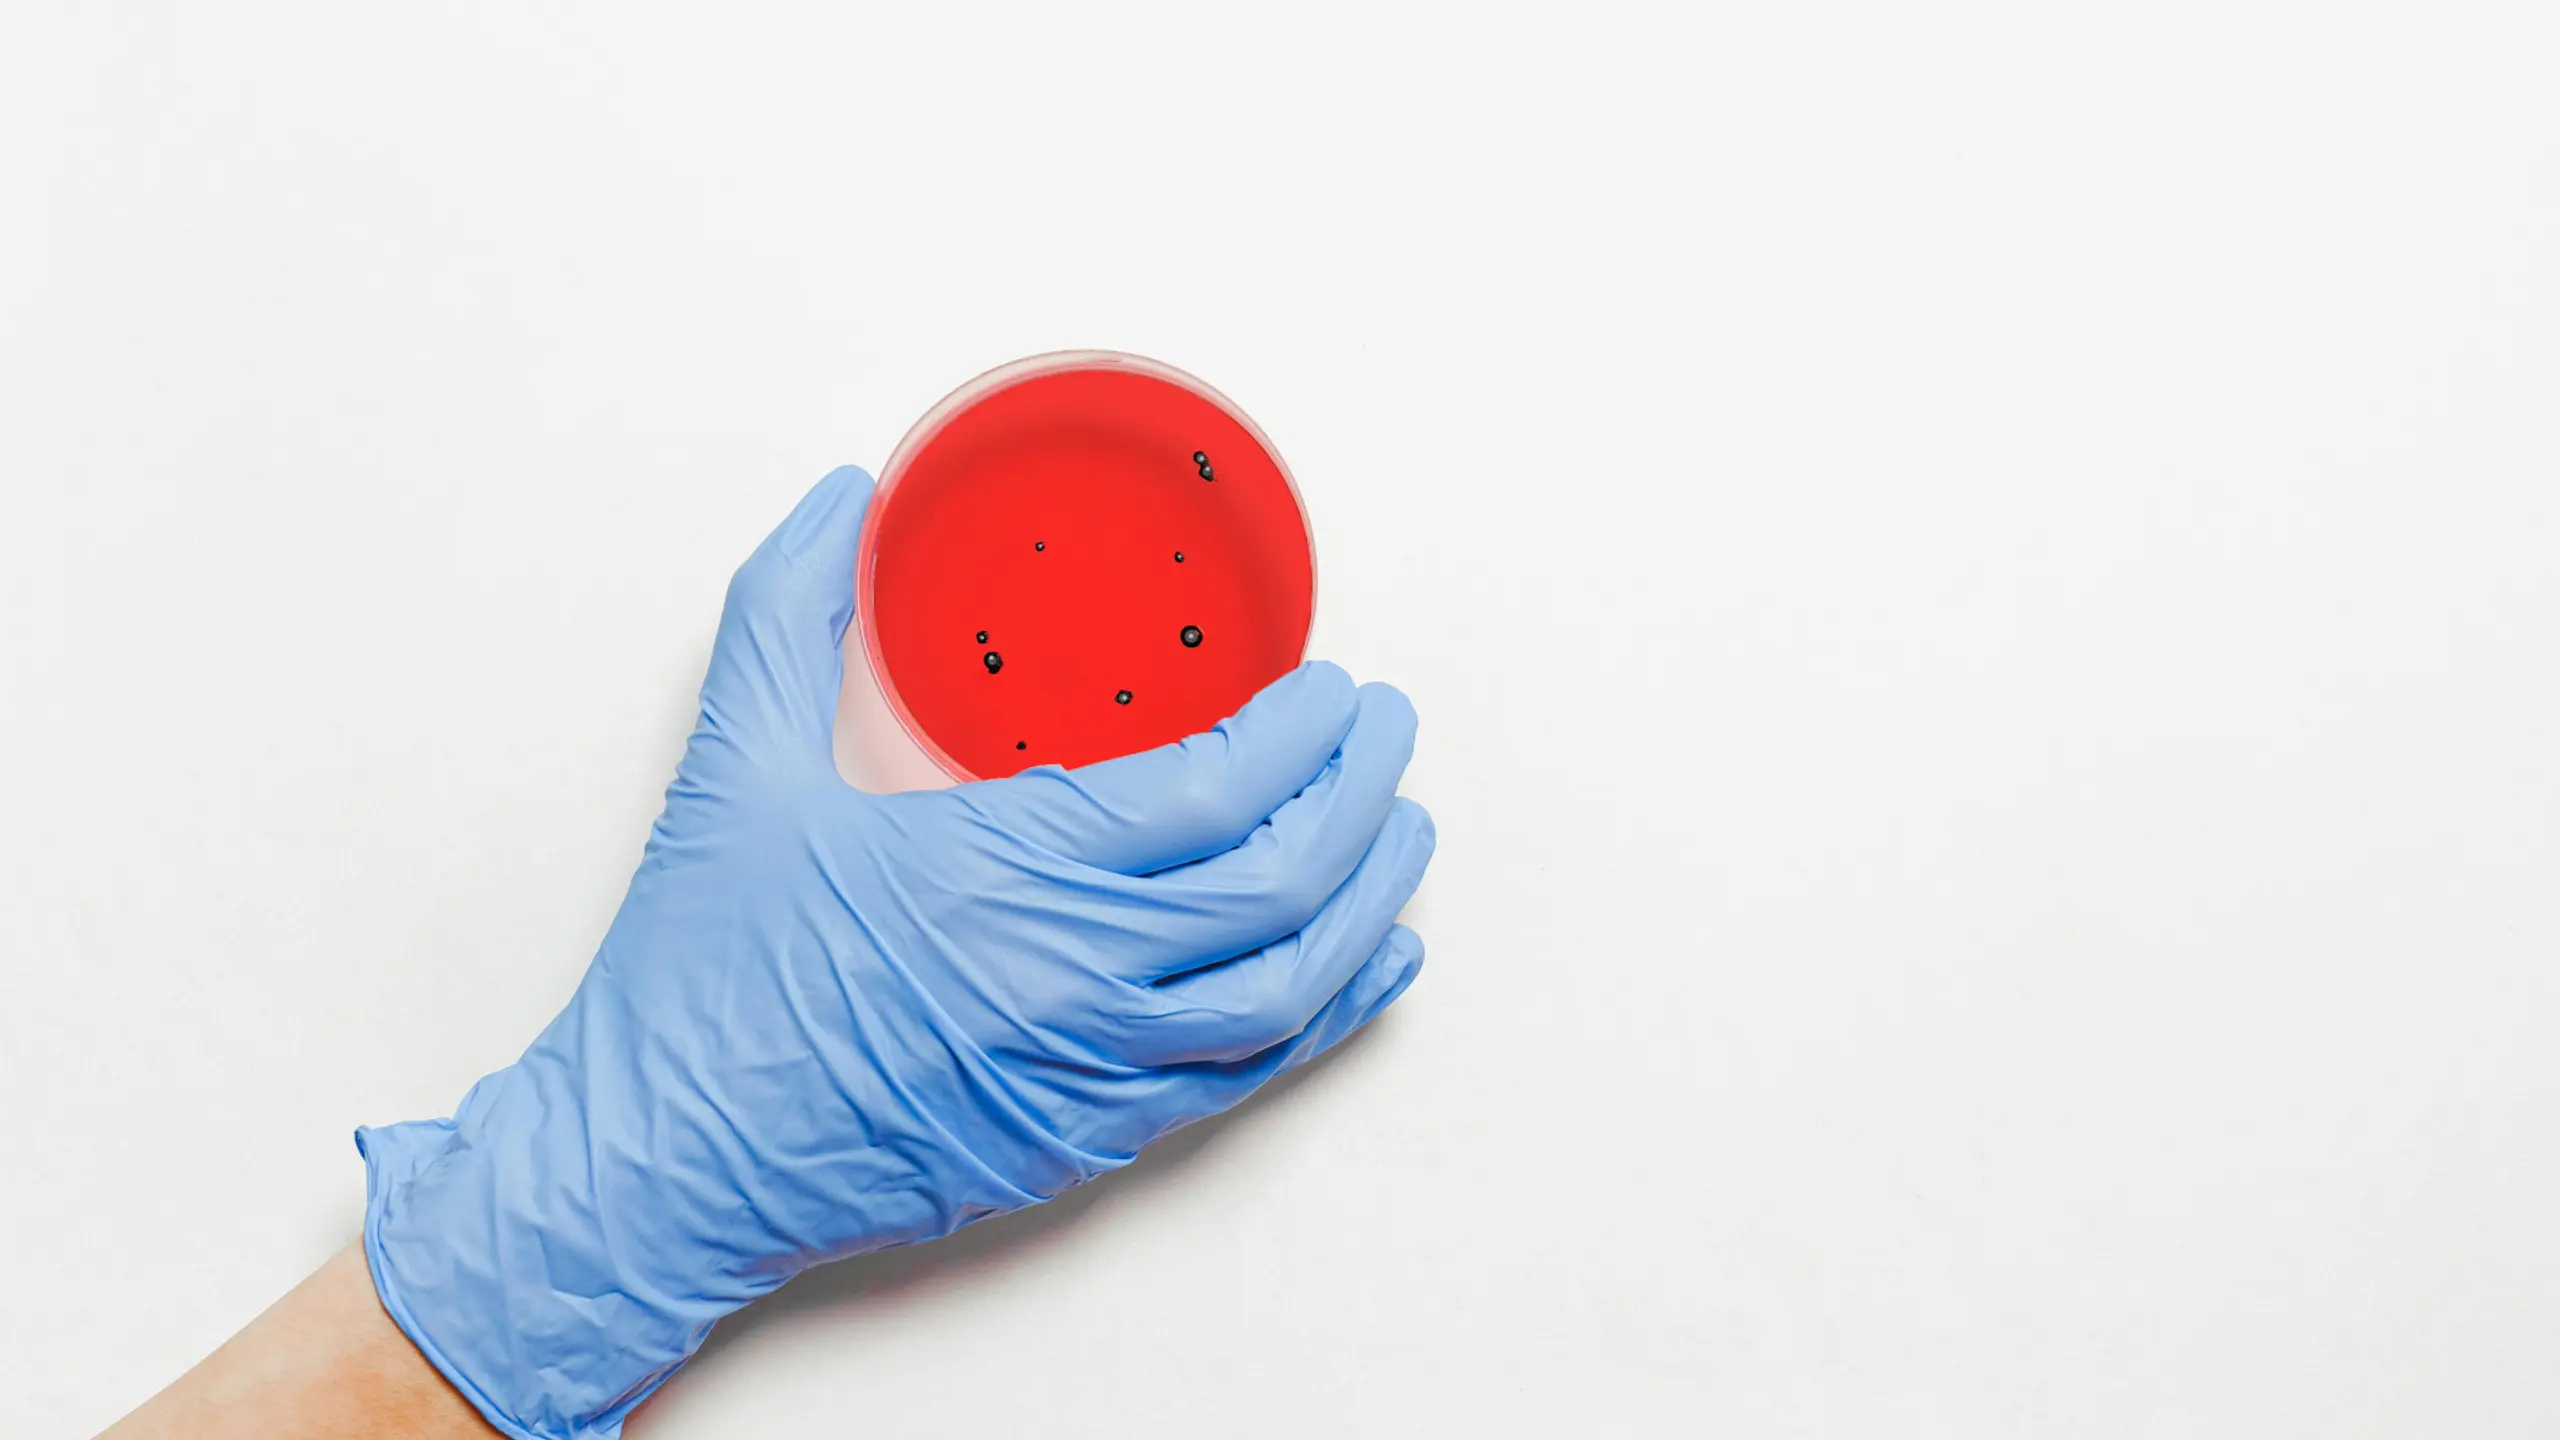
Artikelbild

Der deutsche Geheimdienst sieht laut Medienberichten Hinweise auf riskante sogenannte Gain-of-Function-Experimente sowie Verstöße gegen Vorschriften für Laborsicherheit.
von
Der deutsche Bundesnachrichtendienst (BND) neigt Medienberichten zufolge zu der Einschätzung, dass ein Unfall in einem chinesischen Biolabor Auslöser der weltweiten Corona-Pandemie gewesen sein könnte. Zu dieser Bewertung sei der deutsche Geheimdienst bereits im Jahr 2020 gekommen, berichteten die Süddeutsche Zeitung und die Zeit am Mittwoch.
Grundlage seien neben einer Analyse öffentlicher Daten vor allem Material, das im Rahmen eines nachrichtendienstlichen Einsatzes mit dem Codenamen „Saaremaa“ beschafft worden sei. Dabei handle es sich unter anderem um wissenschaftliche Daten aus chinesischen Forschungseinrichtungen, darunter dem Wuhan-Institut für Virologie. Neben Hinweisen auf riskante sogenannte Gain-of-Function-Experimente der künstlichen Veränderung von in der Natur vorkommenden Viren soll das Material demnach auch zahlreiche Verstöße gegen Vorschriften für die Laborsicherheit nachweisen.
Uneinigkeit unter Forschern
Laut einem Bericht der Neuen Zürcher Zeitung (NZZ) gab es in den vergangenen Wochen einen Austausch mehrerer spezialisierter Wissenschaftler beim BND, in den auch das deutsche Kanzleramt eingebunden gewesen sei. Nach ausgiebigen Untersuchungen lägen zahlreiche Indizien für eine Laborherkunft vor.
Allerdings schreibt die NZZ auch, dass nicht alle beteiligten Forscher gleichermaßen überzeugt seien, dass das Virus eindeutig aus dem Labor kommt. Einige sähen aber eine wachsende Wahrscheinlichkeit, dass das Virus aus dem Wuhan Institute of Virology stamme. Der BND wollte sich zu den Berichten auf Anfrage nicht äußern.
Hochpolitische Frage
Seit Ausbruch der Pandemie Ende 2019 in der chinesischen Stadt Wuhan gibt es Diskussionen darüber, ob das Virus aus einem Labor stammt oder von Tieren auf einem Markt auf den Menschen übertragen wurde. Die chinesische Regierung bestreitet die Labor-Version vehement. Hintergrund der Debatte ist auch, dass in China in Laboren an sogenannten Sars-ähnlichen Corona-Viren gearbeitet wurde. Im Jänner hatte der US-Geheimdienst CIA mitgeteilt, er vermute, dass das Corona-Virus aus einem Labor stamme. Die US-Behörde hatte zuvor jahrelang erklärt, sie könne nicht sagen, ob das Corona-Virus von einem Laborvorfall stamme oder natürlichen Ursprungs sei.
Die Antwort auf die Frage nach der Herkunft des Virus gilt als hochpolitisch. In den vergangenen Jahren sind weltweit Hunderte Millionen Menschen erkrankt und Millionen verstorben. Die Pandemie führte zudem zu einem dramatischen Wirtschaftseinbruch weltweit und gesellschaftlichen Spannungen.